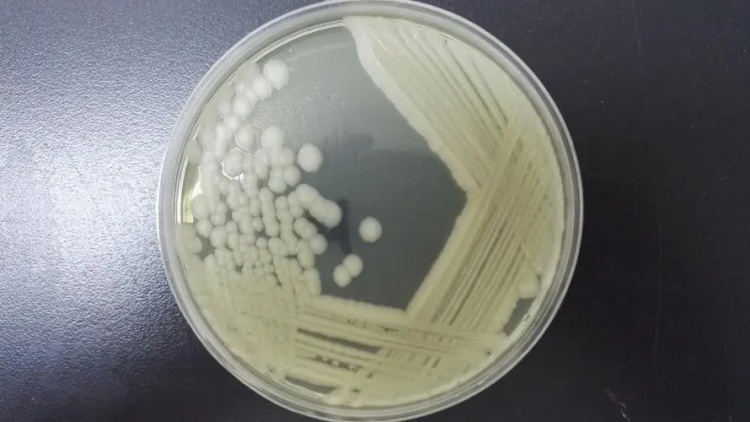
蠟樣芽孢桿菌

乳品中的蠟樣芽孢桿菌污染產(chǎn)生嘔吐毒素對(duì)人體的危害
蠟樣芽孢桿菌是一種常見的細(xì)菌,它可以在不同的食品中被檢測(cè)到,其中包括生牛乳、巴氏奶和嬰兒配方奶粉。這種細(xì)菌在適當(dāng)?shù)沫h(huán)境條件下可以生長(zhǎng)和繁殖,并且能產(chǎn)生一種名為嘔吐毒素的有害物質(zhì)。因此,了解蠟樣芽孢桿菌在這些乳制品中的污染情況以及其對(duì)人體的潛在危害非常重要。
生牛乳是直接從奶牛中獲得的乳液,它是許多乳制品的原材料。然而,芽孢是生牛乳污染的主要原因之一。蠟樣芽孢桿菌的芽孢可以來(lái)源于土壤、飼料、墊料等,并且通過(guò)牛乳頭進(jìn)入牛乳中。此外,牛奶加工設(shè)備上的芽孢也可能在后處理過(guò)程中進(jìn)入乳品。需要注意的是,在沒(méi)有經(jīng)過(guò)熱加工的情況下,生牛乳中的芽孢不會(huì)發(fā)芽,并且蠟樣芽孢桿菌的生長(zhǎng)也會(huì)受到競(jìng)爭(zhēng)性微生物種群的抑制。
然而,當(dāng)生牛乳中的蠟樣芽孢達(dá)到一定的數(shù)量(5 log CFU/mL)時(shí),它就有可能開始產(chǎn)生嘔吐毒素。此外,生牛乳在不同的環(huán)境溫度下的加工或存放也可能促使嘔吐毒素的產(chǎn)生。因此,在生產(chǎn)和儲(chǔ)存過(guò)程中,必須采取適當(dāng)?shù)男l(wèi)生措施,以避免蠟樣芽孢桿菌的污染和嘔吐毒素的產(chǎn)生。
巴氏奶是一種通過(guò)加熱殺菌來(lái)降低細(xì)菌數(shù)量的乳制品。然而,60℃加熱30分鐘的低溫長(zhǎng)時(shí)巴氏殺菌方法不能有效地殺滅蠟樣芽孢桿菌的孢子。相反,這種溫度范圍內(nèi)的加熱反而會(huì)促使芽孢的萌發(fā)。因此,特別是低溫長(zhǎng)時(shí)殺菌方法可能為蠟樣芽孢桿菌的萌發(fā)提供了足夠的溫度和時(shí)間。如果沒(méi)有及時(shí)對(duì)巴氏滅菌乳進(jìn)行冷藏,蠟樣芽孢桿菌就有可能生長(zhǎng)、繁殖甚至產(chǎn)生毒素。
嬰兒配方奶粉是用于代替母乳喂養(yǎng)嬰兒的人造乳制品。為了確保其營(yíng)養(yǎng)價(jià)值和成分接近母乳,常常向配方奶粉中添加一定量的營(yíng)養(yǎng)素。然而,一些營(yíng)養(yǎng)物質(zhì)對(duì)嘔吐毒素的生產(chǎn)具有促進(jìn)作用。其中,L-構(gòu)型的氨基酸對(duì)嘔吐毒素多肽鏈的合成至關(guān)重要。實(shí)驗(yàn)結(jié)果表明,在培養(yǎng)基中添加L-構(gòu)型氨基酸可以顯著增加嘔吐毒素的產(chǎn)量。
此外,復(fù)溶的嬰兒配方奶粉的pH值通常在6.8左右。蠟樣芽孢桿菌在中性環(huán)境中容易生長(zhǎng),而在巴氏滅菌乳的pH值(6.7或6.9)下,蠟樣芽孢菌株在15℃的儲(chǔ)存條件下,細(xì)菌數(shù)量會(huì)迅速增加。在24℃下培養(yǎng)48小時(shí)后,蠟樣芽孢桿菌的數(shù)量甚至可以達(dá)到8 log CFU/mL。此外,在24℃下觀察到的完整生長(zhǎng)曲線表明,蠟樣芽孢桿菌在培養(yǎng)8-13小時(shí)后開始產(chǎn)生嘔吐毒素。因此,建議奶粉沖配好后應(yīng)立即食用,不要在室溫下放置過(guò)長(zhǎng)時(shí)間。
綜上所述,蠟樣芽孢桿菌在生牛乳、巴氏奶和嬰兒配方奶粉中普遍存在,并且具有潛在的危害。為了保證食品安全,生產(chǎn)和消費(fèi)者都應(yīng)嚴(yán)格控制產(chǎn)品的衛(wèi)生情況,并避免食用過(guò)期或未經(jīng)適當(dāng)處理的乳制品,特別是嬰兒配方奶粉。


 脫氫乙酸鈉膠體金檢測(cè)卡
脫氫乙酸鈉膠體金檢測(cè)卡 磷酸鹽(保水劑)檢測(cè)儀
磷酸鹽(保水劑)檢測(cè)儀 磷酸鹽(保水劑)快速檢測(cè)試劑盒
磷酸鹽(保水劑)快速檢測(cè)試劑盒 肉類安全檢測(cè)儀
肉類安全檢測(cè)儀 多參數(shù)水質(zhì)快速檢測(cè)儀
多參數(shù)水質(zhì)快速檢測(cè)儀 抗生素殘留快速檢測(cè)儀
抗生素殘留快速檢測(cè)儀 熒光增白劑檢測(cè)儀
熒光增白劑檢測(cè)儀 在線紅外水分儀
在線紅外水分儀 近紅外全光譜水分儀
近紅外全光譜水分儀 農(nóng)藥殘留檢測(cè)卡(膠體金法)
農(nóng)藥殘留檢測(cè)卡(膠體金法) 卡爾-費(fèi)休電量法水分儀
卡爾-費(fèi)休電量法水分儀 烘干法水分測(cè)定儀
烘干法水分測(cè)定儀 藥物殘留快速檢測(cè)儀
藥物殘留快速檢測(cè)儀 瘦肉精快速檢測(cè)儀
瘦肉精快速檢測(cè)儀 明礬(鋁、硫酸鋁鉀)檢測(cè)試劑盒
明礬(鋁、硫酸鋁鉀)檢測(cè)試劑盒 水分快速測(cè)定儀
水分快速測(cè)定儀 手持式ATP熒光檢測(cè)儀
手持式ATP熒光檢測(cè)儀 ATP生物熒光檢測(cè)儀
ATP生物熒光檢測(cè)儀 食用油品質(zhì)快速檢測(cè)儀
食用油品質(zhì)快速檢測(cè)儀 食品色素檢測(cè)儀
食品色素檢測(cè)儀 金標(biāo)讀數(shù)儀
金標(biāo)讀數(shù)儀 熒光定量分析儀
熒光定量分析儀 農(nóng)藥殘毒檢測(cè)儀
農(nóng)藥殘毒檢測(cè)儀 食物中毒檢測(cè)箱
食物中毒檢測(cè)箱 全能型食品安全檢測(cè)箱
全能型食品安全檢測(cè)箱 農(nóng)藥殘留檢測(cè)試劑盒(紙片法)
農(nóng)藥殘留檢測(cè)試劑盒(紙片法) 脫氫乙酸鈉檢測(cè)儀
脫氫乙酸鈉檢測(cè)儀 苯甲酸鈉含量檢測(cè)試劑盒
苯甲酸鈉含量檢測(cè)試劑盒 過(guò)氧化氫(雙氧水)檢測(cè)試劑盒
過(guò)氧化氫(雙氧水)檢測(cè)試劑盒 六通道多功能食品安全檢測(cè)儀
六通道多功能食品安全檢測(cè)儀 醬油氨基酸態(tài)氮檢測(cè)儀
醬油氨基酸態(tài)氮檢測(cè)儀 重金屬鉛快速檢測(cè)卡
重金屬鉛快速檢測(cè)卡 橡膠固含量檢測(cè)儀
橡膠固含量檢測(cè)儀 膠體金水產(chǎn)品藥物殘留檢測(cè)儀
膠體金水產(chǎn)品藥物殘留檢測(cè)儀 全自動(dòng)微量水分測(cè)定儀
全自動(dòng)微量水分測(cè)定儀 赭曲霉毒素A檢測(cè)儀
赭曲霉毒素A檢測(cè)儀 病害肉檢測(cè)儀
病害肉檢測(cè)儀 SF-60鹵素水分測(cè)定儀
SF-60鹵素水分測(cè)定儀 農(nóng)藥殘留檢測(cè)試劑盒
農(nóng)藥殘留檢測(cè)試劑盒 動(dòng)物疫病檢測(cè)儀
動(dòng)物疫病檢測(cè)儀 依維柯食品質(zhì)量安全檢測(cè)車
依維柯食品質(zhì)量安全檢測(cè)車 抗生素藥物殘留檢測(cè)儀
抗生素藥物殘留檢測(cè)儀 黃曲霉毒素檢測(cè)儀
黃曲霉毒素檢測(cè)儀 T-2毒素檢測(cè)儀
T-2毒素檢測(cè)儀 嘔吐毒素?zé)晒舛繖z測(cè)儀
嘔吐毒素?zé)晒舛繖z測(cè)儀 真菌毒素?zé)晒舛繖z測(cè)儀
真菌毒素?zé)晒舛繖z測(cè)儀 農(nóng)產(chǎn)品質(zhì)量安全檢測(cè)儀
農(nóng)產(chǎn)品質(zhì)量安全檢測(cè)儀 便攜式農(nóng)藥殘留檢測(cè)儀
便攜式農(nóng)藥殘留檢測(cè)儀 農(nóng)藥殘留快速檢測(cè)卡
農(nóng)藥殘留快速檢測(cè)卡 便捷式食品安全檢測(cè)儀
便捷式食品安全檢測(cè)儀
 13560713862
13560713862 微信客服
微信客服
 官方公眾號(hào)
官方公眾號(hào)